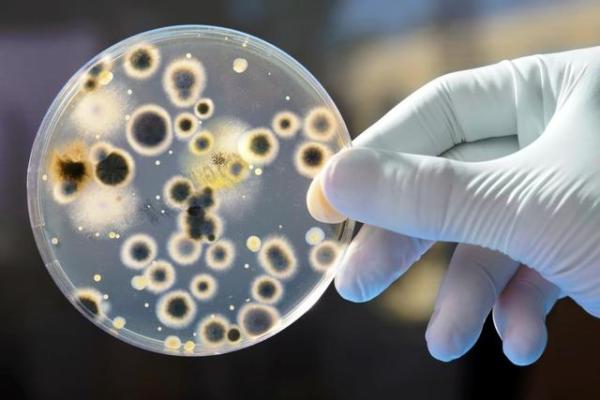

食品是人類(lèi)生存的第一需要,食品安全直接關(guān)系到我們的健康���,影響人類(lèi)的發(fā)展����。食品安全重于泰山��,這是一個(gè)永恒的話(huà)題�����。我們天天和食品打交道,我們每天的生活都離不開(kāi)食品給予的營(yíng)養(yǎng)����。所以,食品可以說(shuō)是我們的脊梁�����、我們的根本�����。我們也要時(shí)時(shí)敲響食品安全的警鐘����。
注重食品安全、倡導(dǎo)健康生活已成為社會(huì)共識(shí)�。如中秋月餅的質(zhì)量就需要重重把關(guān)、檢測(cè)��,應(yīng)該檢測(cè)些什么呢����?
一,檢測(cè)食物中的菌落總數(shù)是指示性微生物指標(biāo)��,不是致病菌指標(biāo),反映食品在生產(chǎn)過(guò)程中的衛(wèi)生狀況���。《食品安全國(guó)家標(biāo)準(zhǔn) 糕點(diǎn)����、面包》(GB 7099—2015)中規(guī)定,月餅同一批次產(chǎn)品5個(gè)樣品的菌落總數(shù)檢測(cè)結(jié)果均不得超過(guò)105CFU/g��,且最多允許2個(gè)樣品的檢測(cè)結(jié)果超過(guò)104CFU/g��。

二�����,脫氫乙酸及其鈉鹽作為一種廣譜食品防腐劑��,對(duì)霉菌和酵母菌的抑制能力強(qiáng)��。脫氫乙酸及其鈉鹽能被人體完全吸收��,并能抑制人體內(nèi)多種氧化酶���,長(zhǎng)期過(guò)量攝入脫氫乙酸及其鈉鹽會(huì)危害人體健康����。其超標(biāo)可能是生產(chǎn)企業(yè)為防止食品腐敗變質(zhì)超限量使用了該食品添加劑,也可能是其使用的復(fù)配添加劑中該添加劑含量較高��,還可能是在添加過(guò)程中未準(zhǔn)確計(jì)量�。

三,防腐劑是常見(jiàn)的食品添加劑�����,指天然或合成的化學(xué)成分�,用于延緩或抑制由微生物引起的食品腐敗變質(zhì)。在月餅中添加防腐劑能夠平衡月餅的口感和保質(zhì)期�,但長(zhǎng)期使用含有過(guò)量防腐劑的食品會(huì)對(duì)人的身體健康產(chǎn)生危害。

食品不合格會(huì)對(duì)人的身體造成一定的危害�����,因此進(jìn)行食品檢測(cè)不可少���,而進(jìn)行上述檢測(cè)項(xiàng)目�����,少不了儀器儀表的助力來(lái)保障我們的入口安全����。
在月餅質(zhì)量檢測(cè)中,我們需要使用到很多專(zhuān)業(yè)的儀器���,如液相色譜儀����、離子體質(zhì)譜儀��、菌落總數(shù)測(cè)定儀�、防腐劑檢測(cè)儀�����、便攜式酸度計(jì)�、手持式劣質(zhì)油檢測(cè)儀微生物限度檢測(cè)儀等設(shè)備,具備檢測(cè)結(jié)果快����、準(zhǔn)確度高、靈活度強(qiáng)等特點(diǎn)�����,有效地提高了檢測(cè)效率。
另外�,在月餅進(jìn)入市場(chǎng)前,商家可通過(guò)食品檢測(cè)設(shè)備對(duì)成品進(jìn)行自檢����。食品安全檢測(cè)設(shè)備可以準(zhǔn)確地檢測(cè)出食物中是否含有威脅人體的有害物質(zhì)。如果月餅中含有有害物質(zhì)����,該儀器將分析其對(duì)人體的危害,從而防患月餅產(chǎn)品出現(xiàn)食品安全事件����。

伴隨著科技的進(jìn)步,食品檢測(cè)儀器種類(lèi)增多��,可快速檢測(cè)各類(lèi)食品中的甲醛��、二氧化硫��、亞硝酸鹽���、吊白塊���、農(nóng)藥殘留的含量��,這對(duì)于我們檢測(cè)月餅中的成分是否安全提供了保障��。
食品是人門(mén)賴(lài)以生存和發(fā)展的物質(zhì)基礎(chǔ)�����,吃得安全���、吃得放心是對(duì)食品安全最基本的要求����。近年來(lái)國(guó)家不斷強(qiáng)化食品安全執(zhí)法,嚴(yán)厲打擊食品安全違法行為�,同時(shí)完善行業(yè)標(biāo)準(zhǔn)和規(guī)定,規(guī)范相關(guān)月餅企業(yè)的生產(chǎn)和經(jīng)營(yíng)活動(dòng)�����,檢測(cè)行業(yè)中儀器儀表一直在為食品安全護(hù)航�。
 400-800-3875
400-800-3875